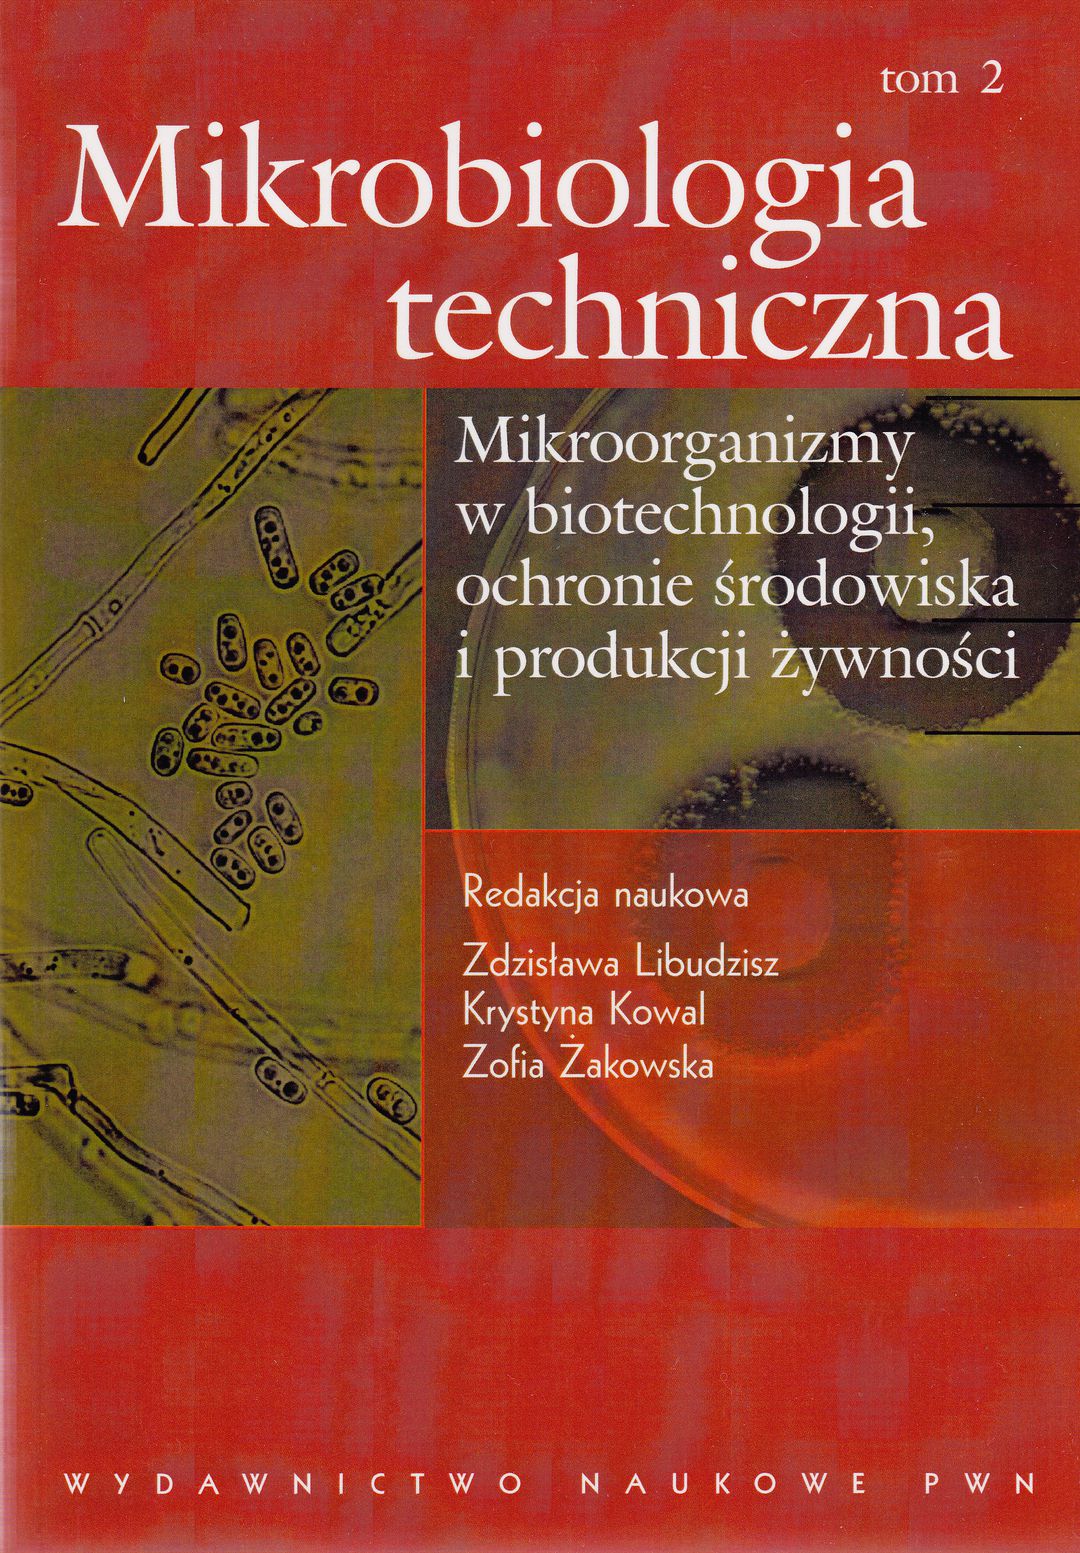

Mikrobiologia techniczna: Mikroorganizmy w biotechnologii, ochronie środowiska i produkcji żywności
| Autor: | Janusz Adamiec |
|---|---|
| Redakcja: | Zdzisława Libudzisz Krystyna Kowal Zofia Żakowska |
| Wydawca: | Wydawnictwo Naukowe PWN (2008-2013) |
| ISBN: | 978-83-01-15222-2, 978-83-01-15523-0 978-83-01-15223-0 |
| Autotagi: | druk książki podręczniki skrypty szkoły wyższe |
|
|
|
|
|
|
Wypożycz w bibliotece
Kup
Recenzje